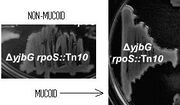

Uploads by James Field
From OpenWetWare
Jump to navigationJump to search
This special page shows all uploaded files.
| Date | Name | Thumbnail | Size | Description |
|---|---|---|---|---|
| 16:42, 29 September 2009 | Bacele.JPG (file) |  |
2 KB | |
| 15:53, 29 September 2009 | DrColi2.JPG (file) |  |
6 KB | |
| 15:17, 29 September 2009 | Bactoblood.JPG (file) |  |
11 KB | |
| 15:14, 29 September 2009 | Taipei.JPG (file) |  |
6 KB | |
| 15:10, 29 September 2009 | DrColi.jpg (file) |  |
12 KB | |
| 14:45, 4 September 2009 | Transition.JPG (file) |  |
13 KB | |
| 08:25, 18 August 2009 | Const6.JPG (file) | 7 KB | ||
| 08:24, 18 August 2009 | Const5.JPG (file) | 6 KB | ||
| 08:23, 18 August 2009 | Const4.JPG (file) | 6 KB | ||
| 08:19, 18 August 2009 | Const1.JPG (file) | 6 KB | Reverted to version as of 08:18, 18 August 2009 | |
| 12:38, 16 August 2009 | Phase3M0.JPG (file) |  |
8 KB | |
| 12:33, 16 August 2009 | Phase2M0.JPG (file) |  |
4 KB | |
| 12:32, 16 August 2009 | Phase1M0.JPG (file) |  |
3 KB | |
| 15:31, 13 August 2009 | MUCOID.JPG (file) | |
9 KB | |
| 14:56, 13 August 2009 | ColanicAssay.JPG (file) |  |
21 KB | |
| 18:41, 11 August 2009 | ColanicAcidTFs.JPG (file) |  |
18 KB | |
| 11:02, 11 August 2009 | Const3.JPG (file) | 5 KB | ||
| 11:02, 11 August 2009 | Const2.JPG (file) | 5 KB | ||
| 10:51, 11 August 2009 | F2620-imp.JPG (file) |  |
3 KB | |
| 16:53, 4 August 2009 | Measure4.JPG (file) |  |
6 KB | |
| 16:52, 4 August 2009 | Measure3.JPG (file) |  |
8 KB | |
| 14:59, 4 August 2009 | Colanic11.JPG (file) |  |
11 KB | |
| 14:56, 4 August 2009 | Colanic10.JPG (file) |  |
8 KB | |
| 14:35, 4 August 2009 | PCV.jpg (file) |  |
30 KB | |
| 19:07, 3 August 2009 | IMPPromoter.JPG (file) |  |
8 KB | |
| 18:56, 3 August 2009 | Module-one.JPG (file) |  |
16 KB | |
| 18:39, 3 August 2009 | Cellulase.JPG (file) | 13 KB | ||
| 18:29, 3 August 2009 | Pah.JPG (file) | 13 KB | ||
| 14:47, 3 August 2009 | Timer6.JPG (file) |  |
28 KB | |
| 12:26, 3 August 2009 | CA.JPG (file) |  |
9 KB | |
| 11:43, 1 August 2009 | HotIce.jpg (file) |  |
8 KB | |
| 13:07, 31 July 2009 | TimerAtc.JPG (file) |  |
12 KB | |
| 08:36, 31 July 2009 | Double Inverter.JPG (file) |  |
21 KB | |
| 13:49, 30 July 2009 | Timer5.JPG (file) |  |
15 KB | |
| 12:03, 30 July 2009 | Timer3.JPG (file) |  |
14 KB | |
| 11:56, 30 July 2009 | Timer2.JPG (file) |  |
26 KB | |
| 11:49, 30 July 2009 | Timer 4.JPG (file) | 14 KB | ||
| 09:35, 30 July 2009 | Timer1.JPG (file) |  |
24 KB | |
| 15:21, 29 July 2009 | Assembly.JPG (file) |  |
13 KB | |
| 12:13, 29 July 2009 | TimerTesting.JPG (file) |  |
42 KB | |
| 10:02, 29 July 2009 | Prelim.JPG (file) |  |
42 KB | |
| 13:56, 28 July 2009 | Prelim.jpg (file) |  |
57 KB | |
| 10:47, 24 July 2009 | MLPS.JPG (file) |  |
43 KB | |
| 10:41, 24 July 2009 | O-antigen.jpg (file) |  |
18 KB | |
| 08:50, 24 July 2009 | Trophic.gif (file) |  |
28 KB | |
| 20:33, 23 July 2009 | B3023.jpg (file) |  |
19 KB | |
| 20:33, 23 July 2009 | B3023.JPG (file) |  |
19 KB | |
| 15:15, 23 July 2009 | Rcs.jpg (file) |  |
91 KB | |
| 11:56, 23 July 2009 | Colanic1.jpg (file) |  |
1.01 MB | |
| 21:24, 17 July 2009 | Crystal Nucleation.jpg (file) |  |
50 KB |